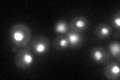
YMR016C
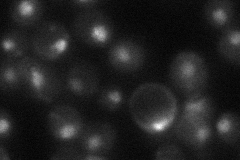
YMR016C
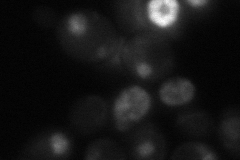
YMR016C
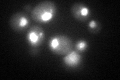
YMR016C

View description
Nuclear protein that plays a regulatory role in the cyclic AMP (cAMP)-dependent protein kinase (PKA) signal transduction pathway; negatively regulates pseudohyphal differentiation; homologous to several transcription factors
Localization:
Intensity:
Fold change:
Significance:
-
C’ GFP library in SD
nucleus44.87 -
N' NOP1pr-GFP in SD

nucleolus62.8035 -
N' TEF2pr-mCherry in SD

missing0 -
N' NATIVEpr-GFP in SD
nucleus29.054 -
N' TEF2pr-VC and Cyto-VN in SD
punctate,nucleus39.0917 -
C’ GFP library in SD+DTT
nucleus50.561.12No -
C’ GFP library in SD+H2O2

nucleus46.071.02No -
C’ GFP library in Starvation Media

nucleus37.20.82No -
C’ GFP library on the background of Pup2-DaMP

nucleus -
C’ GFP library on the background of CCT mutant

nucleus40.88570.91103No
